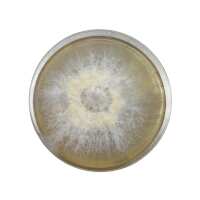

Rootlab develops mushroom growing kits, liquid cultures and equipment that make growing mushrooms in your own home easy - and fun! We also supply thoroughly tested mushroom cultures/spawn & supplies to boutique mushroom farms across Australia.
Visit Website416399905
info@rootlab.com.au
Marrickville,
Sydney
New South Wales
2204